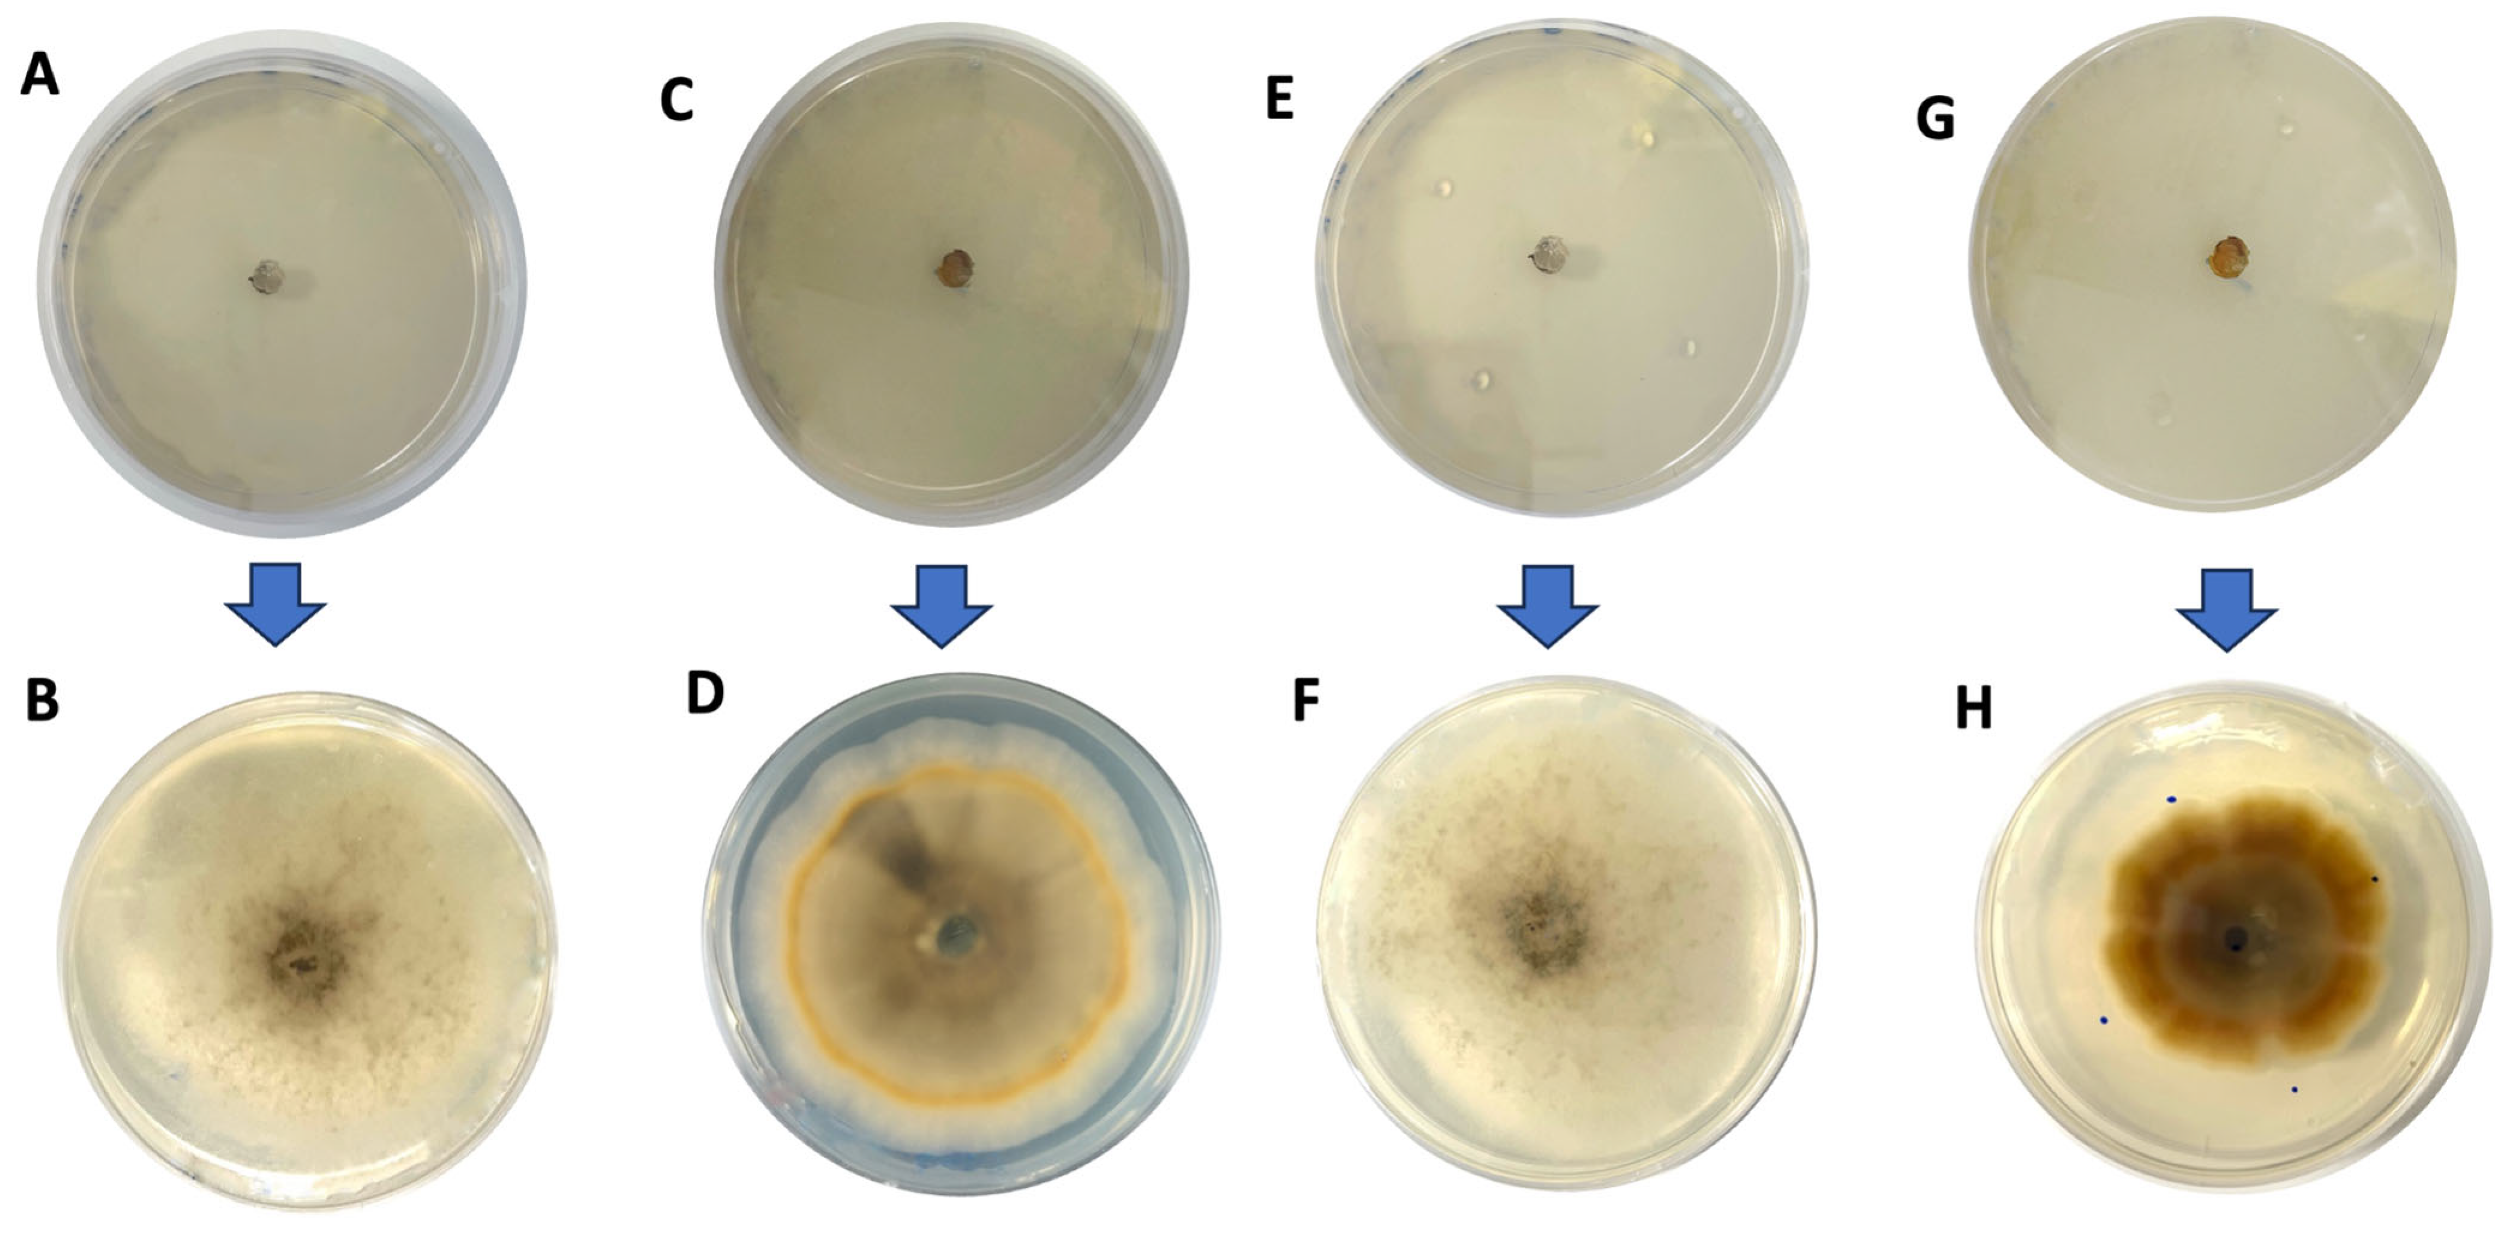
Sustainability 16 08596 g003

Quince (Cydonia oblonga Mill.) Waste By-Product Characterization as a Potential Functional Ingredient
Abstract
1. Introduction
2. Materials and Methods
2.1. Raw Material
2.2. Nutritional Parameters
2.3. Antioxidant Capacity
2.3.1. Sample Processing
2.3.2. Extraction
2.3.3. Antioxidant Capacity Determination
2.4. Antimicrobial Capacity
3. Results and Discussion
3.1. Nutritional Composition
3.2. Antioxidant Capacity
3.3. Antimicrobial Capacity
4. Conclusions
Author Contributions
Funding
Institutional Review Board Statement
Informed Consent Statement
Data Availability Statement
Conflicts of Interest
References
- Romero, J.; Albertos, I.; Díez-Méndez, A.; Poveda, J. Control of postharvest diseases in berries through edible coatings and bacterial probiotics. Sci. Hortic. 2022, 304, 111326. [Google Scholar] [CrossRef]
- Bayram, B.; Ozkan, G.; Kostka, T.; Capanoglu, E.; Esatbeyoglu, T. Valorization and application of fruit and vegetable wastes and by-products for food packaging materials. Molecules 2021, 26, 4031. [Google Scholar] [CrossRef] [PubMed]
- Silva, V.; Silva, A.; Ribeiro, J.; Aires, A.; Carvalho, R.; Amaral, J.S.; Barros, L.; Igrejas, G.; Poeta, P. Screening of chemical composition, antimicrobial and antioxidant activities in pomegranate, quince, and persimmon leaf, peel, and seed: Valorization of autumn fruits by-products for a one health perspective. Antibiotics 2023, 12, 1086. [Google Scholar] [CrossRef] [PubMed]
- Plazzotta, S.; Cottes, M.; Simeoni, P.; Manzocco, L. Evaluating the environmental and economic impact of fruit and vegetable waste valorisation: The lettuce waste study-case. J. Clean. Prod. 2020, 262, 121435. [Google Scholar] [CrossRef]
- Lau, K.Q.; Sabran, M.R.; Shafie, S.R. Utilization of vegetable and fruit by-products as functional ingredient and food. Front. Nutr. 2021, 8, 661693. [Google Scholar] [CrossRef]
- Batool, F.; Kurniawan, T.A.; Mohyuddin, A.; Othman, M.H.; Aziz, F.; Al-Hazmi, H.; Goh, H.H.; Anouzla, A. Environmental impacts of food waste management technologies: A critical review of life cycle assessment (LCA) studies. Trends Food Sci. Technol. 2023, 143, 104287. [Google Scholar] [CrossRef]
- Chandan, A.; John, M.; Potdar, V. Achieving UN SDGs in food supply chain using blockchain technology. Sustainability 2023, 15, 2109. [Google Scholar] [CrossRef]
- Kroll, C.; Warchold, A.; Pradhan, P. Sustainable Development Goals (SDGs): Are we successful in turning trade-offs into synergies? Palgrave Commun. 2019, 5, 140. [Google Scholar] [CrossRef]
- Milho, C.; Silva, J.; Guimarães, R.; Ferreira, I.C.; Barros, L.; Alves, M.J. Antimicrobials from medicinal plants: An emergent strategy to control oral biofilms. Appl. Sci. 2021, 11, 4020. [Google Scholar] [CrossRef]
- Okonogi, S.; Duangrat, C.; Anuchpreeda, S.; Tachakittirungrod, S.; Chowwanapoonpohn, S. Comparison of antioxidant capacities and cytotoxicities of certain fruit peels. Food Chem. 2007, 103, 839–846. [Google Scholar] [CrossRef]
- Mutahar, S.S.; Mutlag, M.A.O.; Najeeb, S.A.Z. Antioxidant activity of pomegranate (Punica granatum L.) fruit peels. Food Nutr. Sci. 2012, 3, 20499. [Google Scholar] [CrossRef]
- Chen, J.; Liao, C.; Ouyang, X.; Kahramanoğlu, I.; Gan, Y.; Li, M. Antimicrobial activity of pomegranate peel and its applications on food preservation. J. Food Qual. 2020, 2020, 8850339. [Google Scholar] [CrossRef]
- Abu-Niaaj, L.F.; Al-Daghistani, H.I.; Katampe, I.; Abu-Irmaileh, B.; Bustanji, Y.K. Pomegranate peel: Bioactivities as antimicrobial and cytotoxic agents. Food Sci. Nutr. 2024, 12, 2818–2832. [Google Scholar] [CrossRef] [PubMed]
- Lai, C.S.; Li, S.; Miyauchi, Y.; Suzawa, M.; Ho, C.T.; Pan, M.H. Potent anti-cancer effects of citrus peel flavonoids in human prostate xenograft tumors. Food Funct. 2013, 4, 944–949. [Google Scholar] [CrossRef] [PubMed]
- Rodríguez-González, S.; Gutiérrez-Ruíz, I.M.; Pérez-Ramírez, I.F.; Mora, O.; Ramos-Gomez, M.; Reynoso-Camacho, R. Mechanisms related to the anti-diabetic properties of mango (Mangifera indica L.) juice by-product. J. Funct. Foods 2017, 37, 190–199. [Google Scholar] [CrossRef]
- Caballero, B.; Trugo, L.; Finglas, P. Encyclopedia of Food Sciences and Nutrition, 2nd ed.; Elsevier Science B.V: Amsterdam, The Netherlands, 2003; p. 6601. [Google Scholar]
- Bayav, A.; Şahin, M. Global economic importance of quince: Current situation, forecasting, and competitiveness analysis. Erwerbs-Obstbau 2023, 65, 509–520. [Google Scholar] [CrossRef]
- Ňorbová, M.; Vollmannová, A.; Fedorková, S.; Musilová, J.; Lidiková, J. The forgotten fruit (Cydonia oblonga Mill.) and its chemicals composition: A review. Eur. Food Res. Technol. 2024, 250, 2093–2102. [Google Scholar] [CrossRef]
- Food and Agriculture Organization of the United Nations. World Food and Agriculture-Statistical Yearbook 2020; Food and Agriculture Organization of the United Nations: Rome, Italy, 2020. [Google Scholar]
- Codina, M.C.; González, E.J.; Molina, A.; Carmona, M.; Berruga, M.I. Bio-based films from quince by-products: A sustainable alternative for biodegradable food packaging. Food Hydrocoll. 2024, 157, 110395. [Google Scholar] [CrossRef]
- Rather, J.A.; Yousuf, S.; Ashraf, Q.S.; Mir, S.A.; Makroo, H.A.; Majid, D.; Barba, F.J.; Dar, B.N. Nutritional and bioactive composition, nutraceutical potential, food and packaging applications of Cydonia oblonga and its byproducts: A review. J. Food Compos. Anal. 2023, 115, 105000. [Google Scholar] [CrossRef]
- Sun, L.; Liu, H.; Chi, B.; Bian, Y.; Zhou, H.; Tian, Z. Analysis and bioactivity of volatile oil from Cydonia oblonga fruit by GC–MS. Food Anal. Methods 2022, 15, 2725–2733. [Google Scholar] [CrossRef]
- Dranca, F.; Oroian, M. Extraction, purification and characterization of pectin from alternative sources with potential technological applications. Food Res. Int. 2018, 113, 327–350. [Google Scholar] [CrossRef] [PubMed]
- Blanda, G.; Rodriguez-Roque, M.J.; Comandini, P.; Flores-Cordova, M.A.; Salas-Salazar, N.A.; Oscar, C.A.; Soto-Caballero, M.C. Phenolic profile and physicochemical characterization of quince (Cydonia oblonga Mill) fruits at different maturity index. Not. Bot. Horti Agrobot. Cluj-Napoca 2020, 48, 2306–2315. [Google Scholar] [CrossRef]
- Ashraf, M.U.; Muhammad, G.; Hussain, M.A.; Bukhari, S.N. Cydonia oblonga M., a medicinal plant rich in phytonutrients for pharmaceuticals. Front. Pharmacol. 2016, 7, 163. [Google Scholar] [CrossRef] [PubMed]
- Al-Zughbi, I.; Krayem, M. Quince fruit Cydonia oblonga Mill nutritional composition, antioxidative properties, health benefits and consumers preferences towards some industrial quince products: A review. Food Chem. 2022, 393, 133362. [Google Scholar] [CrossRef] [PubMed]
- De Bellis, R.; Chiarantini, L.; Potenza, L.; Gorassini, A.; Verardo, G.; De Marco, R.; Benayada, L.; Stocchi, V.; Albertini, M.C.; Fraternale, D. High production of secondary metabolites and biological activities of Cydonia oblonga Mill. pulp fruit callus. J. Funct. Foods 2022, 94, 105133. [Google Scholar] [CrossRef]
- Cunniff, P.; Washington, D. Official methods of analysis of AOAC International. J. AOAC Int. 1997, 80, 127A. [Google Scholar]
- AOAC. Official Method 2003.05. In Official Methods of Analysis of AOAC International, 18th ed.; AOAC International: Gaithersburg, MD, USA, 2005. [Google Scholar]
- AOAC. Official Method 923.03. In Official Methods of Analysis of AOAC International, 18th ed.; AOAC International: Gaithersburg, MD, USA, 2005. [Google Scholar]
- AOAC. Methods 968.06 & 992.15. In Official Methods of Analysis of AOAC International, 18th ed.; AOAC International: Gaithersburg, MD, USA, 2005. [Google Scholar]
- Prosky, L.; Asp, N.G.; Schweizer, T.F.; Devries, J.W.; Furda, I. Determination of insoluble, soluble, and total dietary fiber in foods and food products: Interlaboratory study. J. Assoc. Off. Anal. Chem. 1998, 71, 1017–1023. [Google Scholar] [CrossRef]
- AOAC. Official Method 982.14. In Official Methods of Analysis of AOAC International, 15th ed.; AOAC International: Gaithersburg, MD, USA, 1990. [Google Scholar]
- Santos, H.M.; de Higuera, J.M.; de Araujo Nogueira, A.R. In vitro bioaccessibility of essential minerals from raw and cooked Tilapia fillet: Method validation and analysis by synchronous vertical dual view ICP OES. Food Chem. Adv. 2022, 1, 100080. [Google Scholar] [CrossRef]
- Slinkard, K.; Singleton, V.L. Total phenol analyses: Automation and comparison with manual methods. Am. J. Enol. Vitic. 1977, 28, 49–55. [Google Scholar] [CrossRef]
- Re, R.; Pellegrini, N.; Proteggente, A.; Pannala, A.; Yang, M.; Rice-Evans, C. Antioxidant activity applying an improved ABTS radical cation decolorization assay. Free Radic. Biol. Med. 1999, 26, 1231–1237. [Google Scholar] [CrossRef]
- Brand-Williams, W.; Cuvelier, M.E.; Berset, C.L.W.T. Use of a free radical method to evaluate antioxidant activity. LWT-Food Sci. Technol. 1995, 28, 25–30. [Google Scholar] [CrossRef]
- Zicari, G.; Carraro, E.; Bonetta, S. The Regulation (EC) N. 1924/2006 of the European Parliament and of the Council of the 20 december 2006 on nutrition and health claims made no foods. Prog. Nutr. 2007, 9, 264–273. [Google Scholar]
- Othman, S.; Añibarro-Ortega, M.; Dias, M.I.; Ćirić, A.; Mandim, F.; Soković, M.; Ferreira, I.C.; Pinela, J.; Barros, L. Valorization of quince peel into functional food ingredients: A path towards “zero waste” and sustainable food systems. Heliyon 2022, 8, e11042. [Google Scholar] [CrossRef] [PubMed]
- Coimbra, P.; Marona, B.; Henriques, M.H.; Campos, L.; Gomes, D.M.; Vitorino, C.; Sousa, J.J.; Braga, M.E.; Gaspar, M.C. Edible films based on potato and quince peels with potential for the preservation of cured cheese. Food Packag. Shelf Life 2023, 40, 101176. [Google Scholar] [CrossRef]
- Dimitriu, L.; Preda, D.; Constantinescu-Aruxandei, D.; Oancea, F. Quince Pomace: A Source of Fiber Products and Polyphenols. Chem. Proc. 2023, 13, 6. [Google Scholar] [CrossRef]
- Vasileva, A.L.; Durakova, A.G.; Goranova, Z.T.; Kalaydzhiev, H.R. El potencial del producto alimenticio regional membrillo en forma de polvo como una buena fuente de compuestos bioactivos. Preprints 2024, 2024011888. [Google Scholar] [CrossRef]
- Byczkiewicz, S.; Szwajgier, D.; Kobus-Cisowska, J.; Szczepaniak, O.; Szulc, P. Comparative examination of bioactive phytochemicals in quince (Chaenomeles) fruits and their in vitro antioxidant activity. Emir. J. Food Agric. 2021, 33, 293–302. [Google Scholar] [CrossRef]
- Serna, J.; Bergwitz, C. Importance of dietary phosphorus for bone metabolism and healthy aging. Nutrients 2020, 12, 3001. [Google Scholar] [CrossRef]
- Krzepilko, A.; Prazak, R. Quince seeds as a potential source of mineral and biological active compounds. J. Elem. 2023, 28, 107–122. [Google Scholar] [CrossRef]
- Ibrahim Anber, M.M.A.; Asadi-Gharneh, H.A. Evaluation of Yield Components, Bioactive Compounds, Antioxidative Activity and Mineral Composition in Quince Genotypes. Appl. Fruit Sci. 2024, 66, 465–473. [Google Scholar] [CrossRef]
- Theuwissen, E.; Mensink, R.P. Water-soluble dietary fibers and cardiovascular disease. Physiol. Behav. 2008, 94, 285–292. [Google Scholar] [CrossRef] [PubMed]
- Bakr, A.F.; Farag, M.A. Soluble dietary fibers as antihyperlipidemic agents: A comprehensive review to maximize their health benefits. ACS Omega 2023, 8, 24680–24694. [Google Scholar] [CrossRef] [PubMed]
- Dai, F.J.; Chau, C.F. Classification and regulatory perspectives of dietary fiber. J. Food Drug Anal. 2017, 25, 37–42. [Google Scholar] [CrossRef] [PubMed]
- Nie, Y.; Luo, F. Dietary fiber: An opportunity for a global control of hyperlipidemia. Oxid. Med. Cell. Longev. 2021, 2021, 5542342. [Google Scholar] [CrossRef]
- Khan, E.; Ahmad, I.Z. An insight into the prophylactic and therapeutic activities of golden apple (Cydonia oblonga Mill.) for the future cancer care and prevention: A review. Ann. Phytomed 2021, 10, 22–35. [Google Scholar] [CrossRef]
- Rasheed, M.; Hussain, I.; Rafiq, S.; Hayat, I.; Qayyum, A.; Ishaq, S.; Awan, M.S. Chemical composition and antioxidant activity of quince fruit pulp collected from different locations. Int. J. Food Prop. 2018, 21, 2320–2327. [Google Scholar] [CrossRef]
- Hegedűs, A.; Papp, N.; Stefanovits-Bányai, É. Review of nutritional value and putative health-effects of quince (Cydonia oblonga Mill.) fruit. Int. J. Hortic. Sci. 2013, 19, 29–32. [Google Scholar] [CrossRef]
- Benahmed Djilali, A.; Mehraz, R.; Bouacem, K.; Benseddik, A.; Moualek, I.; Nabiev, M.; Benzara, A. Bioactive substances of Cydonia oblonga fruit: Insecticidal effect of tannins on Tribuliumm confusum. Int. J. Fruit Sci. 2021, 21, 721–731. [Google Scholar] [CrossRef]
- Szychowski, P.J.; Lech, K.; Sendra-Nadal, E.; Hernández, F.; Figiel, A.; Wojdyło, A.; Carbonell-Barrachina, Á.A. Kinetics, biocompounds, antioxidant activity, and sensory attributes of quinces as affected by drying method. Food Chem. 2018, 255, 157–164. [Google Scholar] [CrossRef]
- Aguayo-Rojas, J.; Mora-Rochín, S.; Tovar-Jiménez, X.; Navarro-Cortez, R.O.; Valdez-Morales, M.; Ayala-Lujan, J.L. Phenolic compounds, antioxidant capacity and antihypertensive activity of quince (Cydonia oblonga Miller) harvested in Zacatecas. Polibotánica 2024, 57, 199–212. [Google Scholar] [CrossRef]
- Tarighi, S.; Nejad, M.S. Ecofriendly fabrication of silver nanoparticles using quince petal extract and its antibacterial properties against fire blight disease. J. Nat. Pestic. Res. 2023, 4, 100026. [Google Scholar] [CrossRef]
- Lykholat, Y.V.; Didur, O.O.; Drehval, O.A.; Khromykh, N.O.; Sklyar, T.V.; Lykholat, T.Y.; Liashenko, O.V.; Kovalenko, I.M. Endophytic community of Chaenomeles speciosa fruits: Screening for biodiversity and antifungal activity. Regul. Mech. Biosyst. 2020, 13, 130–136. [Google Scholar] [CrossRef]
- Altuntas, S.; Korukluoglu, M. Biological activity of optimized phenolic extracts of quince (Cydonia oblonga Miller) parts before and after simulated in vitro gastrointestinal digestion. Food Chem. 2024, 437, 137846. [Google Scholar] [CrossRef] [PubMed]
- Maghsoudlou, Y.; Asghari Ghajari, M.; Tavasoli, S. Effects of heat treatment on the phenolic compounds and antioxidant capacity of quince fruit and its tisane’s sensory properties. J. Food Sci. Technol. 2019, 56, 2365–2372. [Google Scholar] [CrossRef]
- Anna, B.; Vizma, N.; Dmitry, B. Anti-Helicobacter activity of certain food plant extracts and juices and their composition in vitro. Food Nutr. Sci. 2011, 2, 7889. [Google Scholar]
- Lima, M.D.C.; De Sousa, C.P.; Fernandez-Prada, C.; Harel, J.; Dubreuil, J.D.; De Souza, E.L. A review of the current evidence of fruit phenolic compounds as potential antimicrobials against pathogenic bacteria. Microb. Pathog. 2011, 130, 259–270. [Google Scholar] [CrossRef]

| Soluble Fiber (g/100 g WB) | Insoluble Fiber (g/100 g WB) | Total Sugars (g/100 g WB) | Vitamin C (g/100 g WB) | Calcium (g/100 g WB) | Magnesium (g/100 g WB) | Potassium (g/100 g WB) |
|---|---|---|---|---|---|---|
| 2.2 ± 1.23 | 12.6 ± 0.32 | 7.4 ± 2.47 | <0.02 ± 0.01 | 0.056 ± 0.01 | 0.024 ± 0.08 | 0.21 ± 0.52 |
| Sample | TCP (mg of GAE) | DPPH (% of Inhibition) | TEAC (µmol TE 100 g 1) |
|---|---|---|---|
| Direct sample | n.m 1 | 47.88 ± 3.57 2 | 31.49 ± 6.12 2 |
| Extract | 22.62 ± 1.34 2 | 72.39 ± 2.77 2 | 377.10 ± 48.09 2 |
Disclaimer/Publisher’s Note: The statements, opinions and data contained in all publications are solely those of the individual author(s) and contributor(s) and not of MDPI and/or the editor(s). MDPI and/or the editor(s) disclaim responsibility for any injury to people or property resulting from any ideas, methods, instructions or products referred to in the content. |
© 2024 by the authors. Licensee MDPI, Basel, Switzerland. This article is an open access article distributed under the terms and conditions of the Creative Commons Attribution (CC BY) license (https://creativecommons.org/licenses/by/4.0/).
Share and Cite
Romero, J.; Díez Méndez, A.; Castro-Alija, M.J.; Poveda, J.; Albertos, I. Quince (Cydonia oblonga Mill.) Waste By-Product Characterization as a Potential Functional Ingredient. Sustainability 2024, 16, 8596. https://doi.org/10.3390/su16198596
Romero J, Díez Méndez A, Castro-Alija MJ, Poveda J, Albertos I. Quince (Cydonia oblonga Mill.) Waste By-Product Characterization as a Potential Functional Ingredient. Sustainability. 2024; 16(19):8596. https://doi.org/10.3390/su16198596
Chicago/Turabian StyleRomero, Janira, Alexandra Díez Méndez, María José Castro-Alija, Jorge Poveda, and Irene Albertos. 2024. "Quince (Cydonia oblonga Mill.) Waste By-Product Characterization as a Potential Functional Ingredient" Sustainability 16, no. 19: 8596. https://doi.org/10.3390/su16198596
APA StyleRomero, J., Díez Méndez, A., Castro-Alija, M. J., Poveda, J., & Albertos, I. (2024). Quince (Cydonia oblonga Mill.) Waste By-Product Characterization as a Potential Functional Ingredient. Sustainability, 16(19), 8596. https://doi.org/10.3390/su16198596

